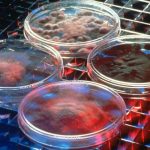

Rebecca Parsons is CTO at ThoughtWorks. Rebecca has more than 30 years’ experience leading the creation of large-scale distributed, services-based applications and the integration of disparate systems. Previously, she was an assistant professor of computer science at the University of Central Florida, where she taught courses on compilers, program optimization, distributed computation, programming languages, the theory of computation, machine learning, and computational biology, and a director’s postdoctoral fellow at the Los Alamos National Laboratory, where her research included work on parallel and distributed computation, genetic algorithms, computational biology, and nonlinear dynamical systems. Rebecca’s interests include parallel and distributed computation, programming languages, domain-specific languages, evolutionary architecture, genetic algorithms, and computational science. She is the co-author of "Domain-Specific Languages," "The ThoughtWorks Anthology," and "Building Evolutionary Architectures." A strong advocate for diversity in the technology industry who is committed to increasing the number of women in coding and STEM fields, Rebecca has served on the board of CodeChix and acted as an advisor to Women Who Code. A sought-after speaker, she has been a featured presenter at well-known conferences, including Collision Conference, Web Summit, YOW!, the Grace Hopper Celebration of Women in Computing, and more. She was chairwoman of the Agile Alliance board of directors for four years and has served the organization over a total of six years. Rebecca holds a BS in computer science and economics from Bradley University and both an MS and a Ph.D. in computer science from Rice University.

Radar article
From the trenches with Rebecca Parsons

Content article
Engineering incremental change
Content article
The evolution of evolutionary architecture

Content article